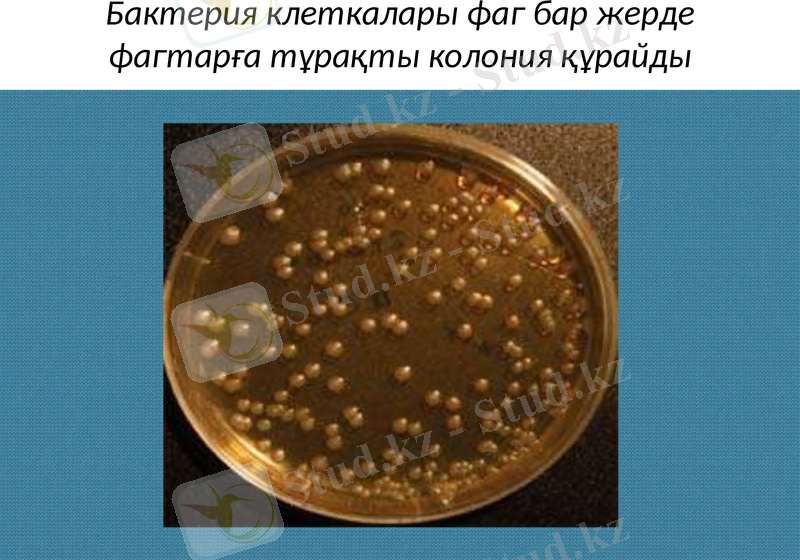
Slide 8

Бактериофагтар: құрылымы, тарихы, систематика және медицинадағы қолданылуы



Бактериофагтар
Қазақ Ұлттық Аграрлық университеті
Микробиология және вирусология кафедрасы
Орындаған: Камал Г.
Шагиров А.
ВМ 203
Тексерген: Жылқайдар А

Жоспар
1. Бактериофагтар
2. Бактериофагтар тарихы
3. Бактериофагтар систематикасы
4. Медицинада қолданылуы

Бактериофагтар (фагтар) (ежелгі грек тілінен аударғанда- жоямын) - бактерия клеткасын жоятын вирустар. Бактериофагтар бактерия ішінде көбейеді және оны ыдыратады. Бактериофаг ақуызды қабаттан және біртізбекті немесе 2 кі тізбекті нуклеин қышқылы бар генетикалық материалдан тұрады. РНҚ немесе ДНҚ. Бөлшектің шамамен ұзындығы 20 дан 200 нмге сәйкес келеді.

Тарихы
Ағылшын бактериологы Туорт Фредрик 1915 жылғы мақаласында стафилакоктардың инфекциялқ ауруын сипаттады, инфицирленген агент фильтрден екіншісіне тасымалдауға болған.
Фредрик Туортқа тәуелсіз француз- канадалық микробиолог Д. Эррель 1917 жылы 3 қыркүйекте бактериофагтардың ашылғаны туралы хабарлайды. Сонымен қатар, Ресейлік микробилог Гамалея Николай Федерович алғаш рет бактерия лизисінің пайда болуын бақылаған.

Бактериофаг ашылған соң Д. Эррель патогенді бактериялардың паразиттері болып табылатын бактериофагтар инфекция патогенезінде маңызды роль атқаратындығын айтты және бактериофагтар адам мен жануар денсаулығын қалпына келтіре отырып, спецификалы иммунитет тудыратыны туралы болжам жасайды. Бұл болжам адамдағы және жануардағы инфекциялық аурулаға қарсы маңызды заттарды фагтардың таппақ болған зерттеушілердің назарын аудартты.

Бактериофагтар систематикасы
Зерттелген бактериофагтардың көпшілігі систематиканы керек етеді.
Қазіргі кезде Халықаралық классификацияға сәйкес бактериофагтар - нуклеин қышқылының түріне байланысты РНҚ лы немесе ДНҚлы болып бөлінеді.
Бактериофагтар химимялық структурасына, нуклеин қышқылының түріне, морфологиясына, және бактерияға әсеріне байланысты ерекшеленеді. Өлшеміне байланысты микроб жасушаларынан жүз тіпті мың есе кіші.

Фаг бөлшегі (вирион) басынан және құйрығынан тұрады. Әдетте ұзындығы басының диаметірінен 2-4 есе үлкен. Вибрионның басында бір тізбекті РНҚлы немесе ДНҚлы транскриптаза ферменті бар генетикалық материал болады. Ол ақуызды немесе липопротеидті қабат - капсиден қоршалған. Фагтар- вирустар сияқты жасуша ішілік паразиттер.
Бактерия клеткалары фаг бар жерде фагтарға тұрақты колония құрайды

Медицинада қолданылуы
Бактериофагтардың негізгі қолданылатын жерлері- антибактериальді терапия. Медецинада стрептокоты, стафилокоты, клебсиеллезді, полмвалентті дизентерийлі, коли, протей және колипротей және тағы басқа бактериофагтар қолданылады.
Бактериофагтар- бактерияға қарсы әсері бар жоғы эффектілі иммунобиологиялық препарат. Қатерлі ішек инфекциясының және іріңді - қабынған аурулар емі мен профилактикасында қолданылады.

Сонымен қатар препараттармен бірге ішек дисбактериозының емінде және ішек микрофлорасын қалпына келтіру үшін қолданылады. Бактериофагтар - тірі агенттер, табиғатта кең таралған бактерия вирустар.

- Іс жүргізу
- Автоматтандыру, Техника
- Алғашқы әскери дайындық
- Астрономия
- Ауыл шаруашылығы
- Банк ісі
- Бизнесті бағалау
- Биология
- Бухгалтерлік іс
- Валеология
- Ветеринария
- География
- Геология, Геофизика, Геодезия
- Дін
- Ет, сүт, шарап өнімдері
- Жалпы тарих
- Жер кадастрі, Жылжымайтын мүлік
- Журналистика
- Информатика
- Кеден ісі
- Маркетинг
- Математика, Геометрия
- Медицина
- Мемлекеттік басқару
- Менеджмент
- Мұнай, Газ
- Мұрағат ісі
- Мәдениеттану
- ОБЖ (Основы безопасности жизнедеятельности)
- Педагогика
- Полиграфия
- Психология
- Салық
- Саясаттану
- Сақтандыру
- Сертификаттау, стандарттау
- Социология, Демография
- Спорт
- Статистика
- Тілтану, Филология
- Тарихи тұлғалар
- Тау-кен ісі
- Транспорт
- Туризм
- Физика
- Философия
- Халықаралық қатынастар
- Химия
- Экология, Қоршаған ортаны қорғау
- Экономика
- Экономикалық география
- Электротехника
- Қазақстан тарихы
- Қаржы
- Құрылыс
- Құқық, Криминалистика
- Әдебиет
- Өнер, музыка
- Өнеркәсіп, Өндіріс
Қазақ тілінде жазылған рефераттар, курстық жұмыстар, дипломдық жұмыстар бойынша біздің қор #1 болып табылады.



Ақпарат
Қосымша
Email: info@stud.kz